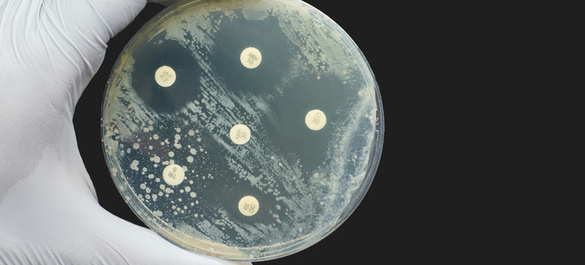
Petri-dish testing for Antimicrobial Susceptibility testing.

Antimicrobial Resistance
Explore our policy work on AMR
The threat of antimicrobial resistance (AMR) has now been recognised globally and it is estimated that 10 million people a year will die due to antimicrobial resistance by 2050 if no urgent action is taken. Explore more of the Microbiology Society’s policy work on antimicrobial resistance below.
Knocking Out AMR
Consultation responses
Briefings
Position statements
Image Credits
iStock/NiseriN
iStock/SweetBunFactory
iStock/Mykola Sosiukin
iStock/librededroit
iStock/lucadp
iStock/anyaivanova
iStock/BrasilNut1
iStock/Nicolae Malancea
iStock/AlexRaths
iStock/Alexey Koza
iStock/angelp
iStock/GOCMEN